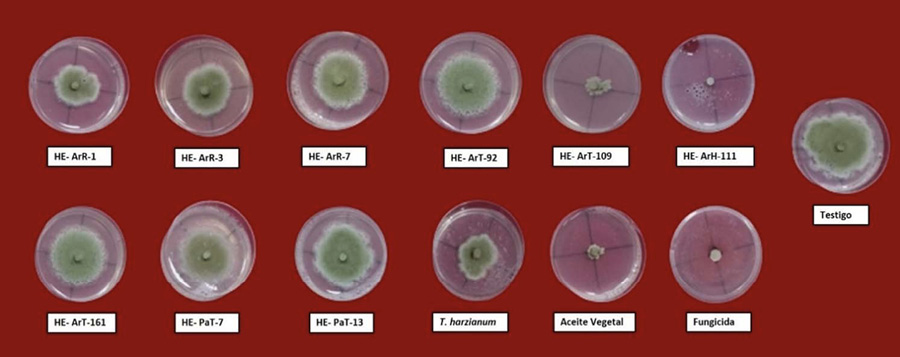

Resumen: Introducción. El “moho verde” causado por Penicillium digitatum es uno de los problemas fitosanitarios que limita la producción en los cítricos. Para su control se utilizan fungicidas sintéticos, que han perdido eficacia, debido a la resistencia generada por el hongo. Una alternativa, es el uso de hongos endófitos con acción biocontroladora. Objetivo. Evaluar el efecto de metabolitos secundarios (MS) de hongos endófitos (HE) en la inhibición micelial de Penicillium digitatum y la eficacia de control de la enfermedad, en frutos de mandarina (Citrus reticulata) después de la cosecha. Materiales y métodos. El estudio se realizó en 2022, bajo un diseño experimental completo al azar, en el laboratorio de Sanidad Vegetal, Universidad Nacional de Cañete (UNDC), Lima, Perú. Para la prueba de antibiosis se extrajeron los metabolitos secundarios de diez cepas de HE de los géneros Trichoderma sp., Fusarium sp. y Aspergillus sp., en donde se evaluó la inhibición micelial del patógeno (%). Se asperjaron MS a una concentración del 15 % (v/v) sobre frutos de mandarina que fueron desinfectados e inoculados con el patógeno por aspersión (1x105 UFC/cc). Adicionalmente, se utilizaron un biocontrol comercial, un aceite vegetal y un fungicida. Después de 6 y 9 días, se evaluaron la incidencia (%) y el índice de severidad (0,1,2,3) de la enfermedad. Resultados. Los metabolitos secundarios de las cepas HEA-111 (Aspergillus), HEA-109 (Fusarium) y HSA-1 (Trichoderma) presentaron la mayor inhibición micelial con 95,05 %, 87,51 % y 47,47 %, respectivamente. En los frutos de mandarina tratados con los MS de las cepas HEA-109 y HSA-1, hubo un control del 80 % y 55 %, respectivamente. Conclusiones. Los MS de HE tuvieron efecto en la inhibición micelial de de P. digitatum y redujeron el avance de la enfermedad en frutos de mandarina después de la cosecha.
Palabras clave: moho, antibiosis, control biológico, antagonismo.
Abstract: Introduction. “Green mold,” caused by Penicillium digitatum is one of the phytosanitary issues that limits citrus production. For its control, synthetic fungicides are used, which have lost effectiveness due to resistance developed by the fungus. An alternative is the use of endophytic fungi with biocontrol action. Objective. To evaluate the effect of secondary metabolites (SM) from endophytic fungi (EF) on the mycelial inhibition of Penicillium digitatum and the effectiveness of disease control in mandarin fruits (Citrus reticulata) post-harvest. Materials and methods. The study was conducted in 2022, using a completely randomized experimental design in the Plant Health Laboratory at the Universidad Nacional de Cañete (UNDC), Lima, Peru. For the antibiosis test, secondary metabolites were extracted from ten strains of EF from the genera Trichoderma sp., Fusarium sp., and Aspergillus sp., where mycelial inhibition of the pathogen (%) was evaluated. SMs were sprayed at 15 % (v/v) concentration on mandarin fruits that were disinfected and inoculated with the pathogen by spraying (1x 105 CFU/cc). Additionally, a commercial biocontrol, a vegetable oil, and a fungicide were used. After 6 and 9 days, disease incidence (%) and severity index (0, 1, 2, 3) were evaluated. Results. Secondary metabolites from strains the HEA-111 (Aspergillus), HEA-109 (Fusarium), and HSA-1 (Trichoderma) showed the highest mycelial inhibition with 95.05 %, 87.51 %, and 47.47 %, respectively. In mandarin fruits treated with SMs from strains HEA-109 and HSA-1, there was a control of 80 % and 55 %, respectively. Conclusions. SMs from EF were effective in inhibiting the mycelial growth of P. digitatum and reduces disease progression in mandarin fruits post-harvest.
Keywords: mold, antibiosis, biological control, antagonism.
Artículos
Biocontrol de Penicillium digitatum con metabolitos secundarios de hongos endófitos en frutos de mandarina*
Biocontrol of Penicillium digitatum with secondary metabolites of endophytic fungi in mandarin fruits

Recepción: 13 Julio 2023
Aprobación: 06 Noviembre 2023
El género Citrus, comprende algunos de los cultivos frutales más cultivados en todo el mundo, incluye un número incierto de especies como naranjas, mandarinas, limas, limones, toronjas y otros (Wu et al., 2018). Son cultivos muy importantes en el Perú, debido a su elevada exportación hacia mercados internacionales, entre los principales departamentos productores de cítricos están: Piura, Lambayeque, Lima, Ica, Junín y Cusco (Ministerio de Agricultura [MINAG], 2023). Los principales mercados mundiales (Estados Unidos, Europa y Asia), muestran una fuerte demanda de cítricos de Perú, en su mayoría de mandarinas sin semillas (Agraria.pe, 2023). Los cítricos son susceptibles a diversos patógenos durante la poscosecha y el transporte, lo que provoca descomposición, deterioro y, por ende, pérdidas económicas (Talibi et al., 2014).
El moho verde causado por Penicillium digitatum, es una importante enfermedad fungosa que daña la calidad del fruto, es responsable de hasta el 90 % de pérdidas del fruto cosechado (Costa et al., 2019). El control de esta enfermedad se logra mediante la aplicación masiva de fungicidas. Sin embargo, su uso indiscriminado tiene implicaciones para la salud y la contaminación ambiental. Los antagonistas microbianos, como los endófitos, son una alternativa prometedora a los fungicidas sintéticos (Li et al., 2022; Wang et al., 2022).
Los hongos endófitos son un grupo de microorganismos que habitan de forma asintomática dentro de todas las plantas; actúan como agentes de control biológico y protegen a la planta de infecciones durante todo su ciclo de vida (Segaran & Sathiavelu, 2019). Como agentes de biocontrol ofrecen inmensas posibilidades para el desarrollo de biofungicidas seguros y ecológicos, debido a los modos de acción utilizados contra los fitopatógenos, tales como: antibiosis, micoparasitismo, competencia por espacio y nutrientes, y resistencia inducida (Gupta & Saxena, 2023). Además, confieren resistencia contra estreses abióticos, generan respuesta de defensa contra el ataque de insectos y patógenos, y promueven el crecimiento vegetal (Khare et al., 2018).
Estos microorganismos son capaces de producir diversas moléculas bioactivas y metabolitos que se aplican en la medicina, la agricultura y la industria (Khare et al., 2018; Nicoletti & Fiorentino, 2015). Estos metabolitos poseen una excelente actividad antifúngica contra los fitopatógenos y pueden ser de naturaleza volátil o no volátil (Deshmukh et al., 2018). Los compuestos orgánicos volátiles (COV) son compuestos que tienen una alta presión de vapor y baja solubilidad en agua, mientras que los metabolitos no volátiles son aquellos que se tardan en vaporizar (Gupta & Saxena, 2023).
La aplicación de hongos endófitos con capacidad antifúngica, puede ayudar a contrarrestar los efectos negativos de los fungicidas sintéticos y permitiría que sean empleados dentro de un plan de Manejo Integrado de Plagas y Enfermedades (MIPE) para el cultivos, como el de mandarina sería una alternativa respetuosa con el ambiente, lo que aumentaría la posibilidad de acceder a mercados internacionales más exigentes. Por lo tanto, la presente investigación tuvo como objetivo evaluar el efecto de metabolitos secundarios (MS) de hongos endófitos (HE) en la inhibición micelial de Penicillium digitatum y la eficacia de control de la enfermedad, en frutos de mandarina después de la cosecha.
Ubicación del experimento
El experimento se ejecutó en el laboratorio de Sanidad Vegetal de la Escuela de Agronomía de la Universidad Nacional de Cañete (UNDC), en el año 2022, ubicado en el distrito de Imperial, provincia de Cañete, departamento de Lima, Perú (13°3’ S, 76°21’ W, 85 m s. n. m.).
Aislamiento de Penicillium digitatum
Se recolectaron muestras de frutos de mandarina (Citrus reticulata) var. Satsuma owari con síntomas y signos de moho verde (Penicillium digitatum), las cuales fueron llevados al laboratorio de Sanidad Vegetal de la UNDC. A las muestras se les extrajo una pequeña porción apical de hifas y conidias de la zona con esporulación, que fue depositada en placas de Petri con medio papa dextrosa agar (PDA), para obtener un cultivo axénico del hongo (Apolonio-Rodríguez et al., 2017). Para la identificación de Penicillium digitatum se realizaron observaciones de las características culturales de la colonia y microscópicas. Se utilizaron las claves de Barnett y Hunter (1998), Barron (1968) y Gómez de Membrillera (1950), para identificación a nivel de especie.
Obtención de hongos endófitos
Las cepas de hongos endófitos fueron proporcionadas por el laboratorio de Sanidad Vegetal de la UNDC. Estas fueron aisladas de hojas, tallos y raíz de plantas de arándano (Vaccinium corymbosum) y papa (Solanum tuberosum), de la región de Ica y Lima, Perú (Leon Ttacca et al., 2022), y conservadas en solución de glicerina al 20 %, a una temperatura de -20 °C (Almaraz Sanchez et al., 2019). Para esta investigación se reactivaron diez cepas (Cuadro 1) en placas Petri con medio de cultivo papa dextrosa agar (PDA) y se incubaron a una temperatura de 25 °C por una semana.

Table 1. Origin of the endophytic fungal strains used in the research. Plant Health Laboratory. Universidad Nacional de Cañete, Lima, Peru, 2022.
Prueba de antibiosis
Se produjeron metabolitos secundarios, solubles e inhibitorios de las diez cepas de hongos endófitos, según la metodología empleada por Leon-Ttacca et al. (2022). Estas cepas se sembraron en placas Petri con medio PDA y se incubaron a 25 ºC durante siete días. Transcurrido el tiempo, se obtuvo una suspensión de esporas (1x106 ufc ml-1), 1 ml de esta suspensión fue depositado en matraces con caldo de papa más sacarosa (100 ml). Tres matraces por cada cepa se incubaron a 25 ºC en agitación a 110 rpm por siete días, luego el micelio fue removido por filtración en la cabina de flujo, el caldo filtrado se centrifugó por 5 min a 3000 rpm, el sobrenadante se colocó en baño maría a 90 ºC por una hora, luego se añadió un volumen igual de PDA (2x de agar) y se transfirieron en placas Petri de 60x15 mm (tres repeticiones por filtrado). En el centro de las placas se inoculó un disco de 5 mm del patógeno Penicillium digitatum de una edad de crecimiento de siete días; las placas con el inóculo fueron incubadas a una temperatura de 25 ºC por cinco días. Para los controles (testigo) se siguió el mismo procedimiento, se emplearon filtrados sin HE (solo caldo de papa más sacarosa). La evaluación se realizó cuando el patógeno colonizó las placas de los testigos. Con ayuda de un vernier digital se registraron las medidas del crecimiento radial de la colonia (mm) del patógeno en cuatro radios de las placas. El porcentaje de inhibición micelial se calculó con la ecuación 1 (Zhang, He, et al., 2022).
(1)Donde: I (%)= porcentaje de inhibición del crecimiento micelial (radial), C= medida del crecimiento radial del patógeno en el control y T= medida de crecimiento radial del patógeno en presencia del biocontrolador.
Biocontrol del moho verde (Penicillium digitatum) con metabolitos secundarios en frutos de mandarina en condiciones de laboratorio
Se recolectaron frutos sanos de mandarina variedad satsuma de una plantación de cuatro años ubicada en el distrito de San Vicente de Cañete, estos fueron transportados con el mayor cuidado posible sin causar heridas hacia el laboratorio de Sanidad Vegetal de la UNDC. Los frutos se lavaron con agua potable, luego se les desinfectó la superficie con hipoclorito de sodio al 2 % por 5 min y enjuagaron tres veces con agua destilada estéril (Zhang, Yin, et al., 2022). Para su secado se colocaron dentro de la cámara de siembra sobre papel toalla. Luego, con una aguja estéril se realizaron cuatro heridas superficiales (1 cm de largo) en cuatro puntos equidistantes de cada fruto, para la inoculación del patógeno. Con un atomizador manual, se asperjó una suspensión de esporas del patógeno (1 x106 ufc ml-1) sobre los frutos, se dejó en incubación por cuatro horas dentro de cajas plásticas, luego se aplicaron los metabolitos secundarios al 15 % sobre la superficie de los frutos inoculados por aspersión. Cada tratamiento tuvo tres repeticiones, cinco frutos por repetición. Los frutos fueron colocados sobre placas Petri dentro de una cámara húmeda (caja plástica con algodón empapado con ADE), se dejaron en incubación durante nueve días a temperatura ambiente (23 °C ± 2) y se evaluó la incidencia y severidad de la enfermedad.
Evaluación de la incidencia y severidad del moho verde (Penicillium digitatum) en frutos de mandarina
Para medir la incidencia, se evaluaron los síntomas y signos en las heridas de los frutos con relación al total de frutos, el resultado se expresó en porcentaje. Para la severidad se empleó una escala de índice de daño (Cocco et al., 2008) y fue adaptada a una escala gráfica en grados (Figura 1): Grado 0 (sin infección), Grado 1 para alteraciones leves (infección sin esporulación), Grado 2 para alteraciones moderadas (esporulación menor al 50 % del tejido afectado) y Grado 3 para alteraciones severas (esporulación mayor al 50 % del tejido afectado). La incidencia, severidad y eficiencia de control de la enfermedad fue calculado con las ecuaciones 2, 3 y 4, respectivamente (Zhang, He, et al., 2022).
(2)
(3)
(4)

Figure 1. Graphical scale for assesing the severity of green mold (Penicillium digitatum) on mandarins (Citrus reticulata). Plant Health Laboratory. Universidad Nacional de Cañete, Lima, Peru, 2022.
Análisis estadístico
El experimento se condujo bajo un diseño completamente al azar con doce tratamientos (HE) y tres repeticiones. Los datos fueron analizados en el software estadístico InfoStat, versión 2008 (Di Rienzo et al., 2008), estos cumplieron los supuestos de normalidad y homogeneidad de varianzas, por lo que se realizó un análisis de varianza y la prueba de rango múltiple de Duncan, con un nivel de significancia de 0,05.
Efecto de metabolitos secundarios (MS) de hongos endófitos (HE) en la inhibición micelial de Penicillium digitatum
En los ensayos in vitro, los metabolitos secundarios (MS) de diez cepas de hongos endófitos variaron en la inhibición micelial de P. digitatum sobre medio PDA en comparación con el testigo, donde siguió creciendo el patógeno (Figura 2). Los MS de las cepas HE-Art-111 (Aspergillus) y HE-Art-109 (Fusarium), mostraron un efecto potencial de inhibición sobre el crecimiento micelial del patógeno con 95,05 % y 87,51 %, respectivamente, con un comportamiento similar a los tratamientos a base de fungicida y aceite vegetal, los que inhibieron por completo el crecimiento micelial del patógeno. La cepa comercial (T. harzianum) y HE-ArR-1, inhibieron en un 64,98 % y 47,48 %, respectivamente, en comparación con el resto de cepas que tuvieron un menor efecto con valores menores a 33,2 % de inhibición micelial del patógeno (Figura 3).

Hongos endófitos (HE) aislados de tejidos de raíz (R), tallo (T) y hoja (H) de plantas de arándano (Ar) y papa (Pa). Cepas 1, 3, 7, 92, 161, 7, 13 pertenecen al género Trichoderma, 109 a Fusarium: y 111 a Aspergillus.
Figure 2. Effect of secondary metabolites of endophytic fungal strains on the mycelial growth of Penicillium digitatum. Plant Health Laboratory, Universidad Nacional de Cañete, Lima, Peru. 2022.
Endophytic fungi (HE) isolated from root (R), stem (T), and leaf (H) tissues of blueberry (Ar) and potato (Pa) plants. Strains 1, 3, 7, 92, 161, 7, 13 belong to the genus Trichoderma; 109 to Fusarium; and 111 to Aspergillus.

Hongos endófitos (HE) aislados de tejidos de raíz ®, tallo (T) y hoja (H) de plantas de arándano (Ar) y papa (Pa). Cepas 1, 3, 7, 92, 161, 7, 13 pertenecen al género Trichoderma, 109 a Fusarium: y 111 a Aspergillus.
Figure 3. Mycelial growth of Penicillium digitatum on potato dextrose agar (PDA) with secondary metabolites from endophytic fungal strains. Plant Health Laboratory, Universidad Nacional de Cañete, Lima, Peru. 2022.
Endophytic fungi (HE) isolated from root (R), stem (T), and leaf (H) tissues of blueberry (Ar) and potato (Pa) plants. Strains 1, 3, 7, 92, 161, 7, 13 belong to the genus Trichoderma; 109 to Fusarium; and 111 to Aspergillus.
Eficacia de biocontrol de metabolitos secundarios de hongos endófitos sobre el moho verde (P. digitatum) en frutos de mandarina durante la poscosecha
A los seis y nueve días de almacenamiento, los frutos tratados con agua destilada e inoculados con esporas de P. digitatum presentaron una incidencia de la enfermedad del 100 % (Testigo), comparado con los frutos de mandarina tratados con metabolitos secundarios que redujeron el desarrollo de la enfermedad (Figura 4). Los MS de la cepa HE-ArT-109 del género Fusarium, fueron los que mejor controlaron la infección del patógeno sobre las heridas del fruto, seguido de cepa HE – ArR-1 del género Trichoderma; sin embargo, los MS de las demás cepas llegaron a presentar incidencia y severidad mayor a 55 % y 41,6 %, respectivamente (Cuadro 2).

Hongos endófitos (HE) aislados de tejidos de raíz (R), tallo (T) y hoja (H) de plantas de arándano (Ar) y papa (Pa). Cepas 1, 3, 7, 92, 161, 7, 13 pertenecen al género Trichoderma, 109 a Fusarium, y 111 a Aspergillus.
Figure 4. Effect of secondary metabolites (SM) from endophytic fungi (HE) on the development of green mold (Penicillium digitatum) disease in mandarin fruits (Citrus reticulata) after 6 and 9 days of storage. Plant Health Laboratory, Universidad Nacional de Cañete, Lima, Peru. 2022.
Endophytic fungi (HE) isolated from root (R), stem (T), and leaf (H) tissues of blueberry (Ar) and potato (Pa) plants. Strains 1, 3, 7, 92, 161, 7, 13 belong to the genus Trichoderma; 109 to Fusarium; and 111 to Aspergillus.

Table 2. Effect of secondary metabolites from endophytic fungi on the incidence and severity of green mold (Penicillium digitatum) on mandarin fruits (Citrus reticulata) after 6 and 9 days of storage. Plant Health Laboratory, Universidad Nacional de Cañete, Lima, Peru. 2022.
La mayor eficacia de biocontrol de MS se dio a los seis días después de la inoculación con P. digitatum sobre frutos de mandarina, con valores comprendidos desde 15 % hasta 85 %. Sin embargo, a los nueve días de almacenamiento presentaron valores de 10 % a 80 % de eficacia de control. Los frutos tratados con fungicida presentaron la mayor eficacia de control (100 %), seguido de los MS de las cepas HE-ArT-109 y HE-ArR-1 con 80 y 55 %, respectivamente (Figura 5).

Hongos endófitos (HE) aislados de tejidos de raíz (R), tallo (T) y hoja (H) de plantas de arándano (Ar) y papa (Pa). Cepas 1, 3, 7, 92, 161, 7, 13 pertenecen al género Trichoderma, 109 a Fusarium, y 111 a Aspergillus.
Figure 5. Efficacy of biocontrol using secondary metabolites from endophytic fungal strains on green mold (Penicillium digitatum) in mandarin fruits (Citrus reticulata) at 6 and 9 days after P. digitatum inoculation. Plant Health Laboratory, Universidad Nacional de Cañete, Lima, Peru. 2022.
Endophytic fungi (HE) isolated from root (R), stem (T), and leaf (H) tissues of blueberry (Ar) and potato (Pa) plants. Strains 1, 3, 7, 92, 161, 7, 13 belong to the genus Trichoderma; 109 to Fusarium; and 111 to Aspergillus.
Los hongos endófitos protegen a la planta huésped del ataque de patógenos a través de la antibiosis con la producción de metabolitos secundarios, el parasitismo y el mecanismo de competencia (Segaran & Sathiavelu, 2019). En esta investigación, con la prueba de antibiosis, los metabolitos secundarios que liberaron las cepas endófitas de los géneros Aspergillus sp., Fusarium sp. y Trichoderma sp., presentaron actividad antifúngica contra P. digitatum, con resultados similares a los tratamientos empleados como control (aceite vegetal y fungicida). Esta inhibición se debe a las múltiples sustancias antifúngicas presentes en los metabolitos extraídos, los cuales pueden actuar sobre o dentro de las células patógenas, y así inferir con el metabolismo de los patógenos (Zhang, Yin, et al., 2022).
Los frutos de mandarina tratados con los metabolitos secundarios mostraron menos síntomas de la enfermedad en comparación con el testigo, con una eficiencia de control del 80 % a los nueve días de almacenamiento. El control efectivo podría atribuirse a la actividad antifúngica que está asociada con la disrupción de la membrana celular, la reducción de las actividades enzimáticas del patógeno y la acumulación de niveles de especies reactivas de oxígeno (ROS) intracelulares en el cuerpo de P. italicum, lo que conlleva a la peroxidación de los lípidos de la membrana y a la apoptosis celular (Zhang, He, et al., 2022). También, el género Fusarium es un productor de metabolitos secundarios antimicrobianos y tiene actividades inhibidoras significativas contra hongos patógenos (Xu et al., 2023).
Estudios señalan que se aislaron e identificaron compuestos del hongo endófito Fusarium sp., que mostraron actividades herbicidas, antifúngicas y antibacterianas (Hussain et al., 2015). Es probable que en los metabolitos extraídos de la cepa 109 del género Fusarium, se encuentre el metabolito secundario Fusaricide, que tambien mostró actividad antifúngica contra Penicillium chrysogenum (McBrien et al., 1996). Lo cual indicaría la eficacia de control de P. digitatum con la aplicación de los MS de la cepa 109 del género Fusarium en los frutos de mandarina durante el almacenamiento. Estos metabolitos activos pueden prevenir el deterioro fúngico de cultivos, frutas y hortalizas, tanto en condiciones de campo como posteriores a la cosecha y podrían alargar la vida útil de productos alimenticios (Deshmukh et al., 2018). El control efectivo del moho verde en los frutos de los cítricos por los metabolitos, puede ser atribuido a los efectos antifúngicos sobre P. digitatum. Estos agentes efectivos para el control biológico pueden reducir de manera segura y efectiva la alta tasa de descomposición de los frutos de los cítricos causada por Penicillium spp. en almacenamiento poscosecha.
Los metabolitos secundarios de las cepas de hongos endófitos del género Aspergillus (HE-ArT-111) y Fusarium (HE-ArT-109), inhibieron el crecimiento micelial de Penicillium digitatum en un 95,05 y 87,51 %, respetivamente. La cepa HE-ArT-109 redujo el desarrollo del moho verde en frutos de mandarina en un 80 %, a los nueve días de almacenamiento.
Los autores reconocen el apoyo financiero a la Universidad Nacional de Cañete, a través del proyecto de investigación “Prospección de enfermedades fungosas en cítricos en el valle de Cañete y su biocontrol in vitro” del semillero de investigación “Control biológico de enfermedades en plantas”.
bleon@undc.edu.pe

Table 1. Origin of the endophytic fungal strains used in the research. Plant Health Laboratory. Universidad Nacional de Cañete, Lima, Peru, 2022.

Figure 1. Graphical scale for assesing the severity of green mold (Penicillium digitatum) on mandarins (Citrus reticulata). Plant Health Laboratory. Universidad Nacional de Cañete, Lima, Peru, 2022.
Hongos endófitos (HE) aislados de tejidos de raíz (R), tallo (T) y hoja (H) de plantas de arándano (Ar) y papa (Pa). Cepas 1, 3, 7, 92, 161, 7, 13 pertenecen al género Trichoderma, 109 a Fusarium: y 111 a Aspergillus.
Figure 2. Effect of secondary metabolites of endophytic fungal strains on the mycelial growth of Penicillium digitatum. Plant Health Laboratory, Universidad Nacional de Cañete, Lima, Peru. 2022.
Endophytic fungi (HE) isolated from root (R), stem (T), and leaf (H) tissues of blueberry (Ar) and potato (Pa) plants. Strains 1, 3, 7, 92, 161, 7, 13 belong to the genus Trichoderma; 109 to Fusarium; and 111 to Aspergillus.

Hongos endófitos (HE) aislados de tejidos de raíz ®, tallo (T) y hoja (H) de plantas de arándano (Ar) y papa (Pa). Cepas 1, 3, 7, 92, 161, 7, 13 pertenecen al género Trichoderma, 109 a Fusarium: y 111 a Aspergillus.
Figure 3. Mycelial growth of Penicillium digitatum on potato dextrose agar (PDA) with secondary metabolites from endophytic fungal strains. Plant Health Laboratory, Universidad Nacional de Cañete, Lima, Peru. 2022.
Endophytic fungi (HE) isolated from root (R), stem (T), and leaf (H) tissues of blueberry (Ar) and potato (Pa) plants. Strains 1, 3, 7, 92, 161, 7, 13 belong to the genus Trichoderma; 109 to Fusarium; and 111 to Aspergillus.

Hongos endófitos (HE) aislados de tejidos de raíz (R), tallo (T) y hoja (H) de plantas de arándano (Ar) y papa (Pa). Cepas 1, 3, 7, 92, 161, 7, 13 pertenecen al género Trichoderma, 109 a Fusarium, y 111 a Aspergillus.
Figure 4. Effect of secondary metabolites (SM) from endophytic fungi (HE) on the development of green mold (Penicillium digitatum) disease in mandarin fruits (Citrus reticulata) after 6 and 9 days of storage. Plant Health Laboratory, Universidad Nacional de Cañete, Lima, Peru. 2022.
Endophytic fungi (HE) isolated from root (R), stem (T), and leaf (H) tissues of blueberry (Ar) and potato (Pa) plants. Strains 1, 3, 7, 92, 161, 7, 13 belong to the genus Trichoderma; 109 to Fusarium; and 111 to Aspergillus.

Table 2. Effect of secondary metabolites from endophytic fungi on the incidence and severity of green mold (Penicillium digitatum) on mandarin fruits (Citrus reticulata) after 6 and 9 days of storage. Plant Health Laboratory, Universidad Nacional de Cañete, Lima, Peru. 2022.

Hongos endófitos (HE) aislados de tejidos de raíz (R), tallo (T) y hoja (H) de plantas de arándano (Ar) y papa (Pa). Cepas 1, 3, 7, 92, 161, 7, 13 pertenecen al género Trichoderma, 109 a Fusarium, y 111 a Aspergillus.
Figure 5. Efficacy of biocontrol using secondary metabolites from endophytic fungal strains on green mold (Penicillium digitatum) in mandarin fruits (Citrus reticulata) at 6 and 9 days after P. digitatum inoculation. Plant Health Laboratory, Universidad Nacional de Cañete, Lima, Peru. 2022.
Endophytic fungi (HE) isolated from root (R), stem (T), and leaf (H) tissues of blueberry (Ar) and potato (Pa) plants. Strains 1, 3, 7, 92, 161, 7, 13 belong to the genus Trichoderma; 109 to Fusarium; and 111 to Aspergillus.